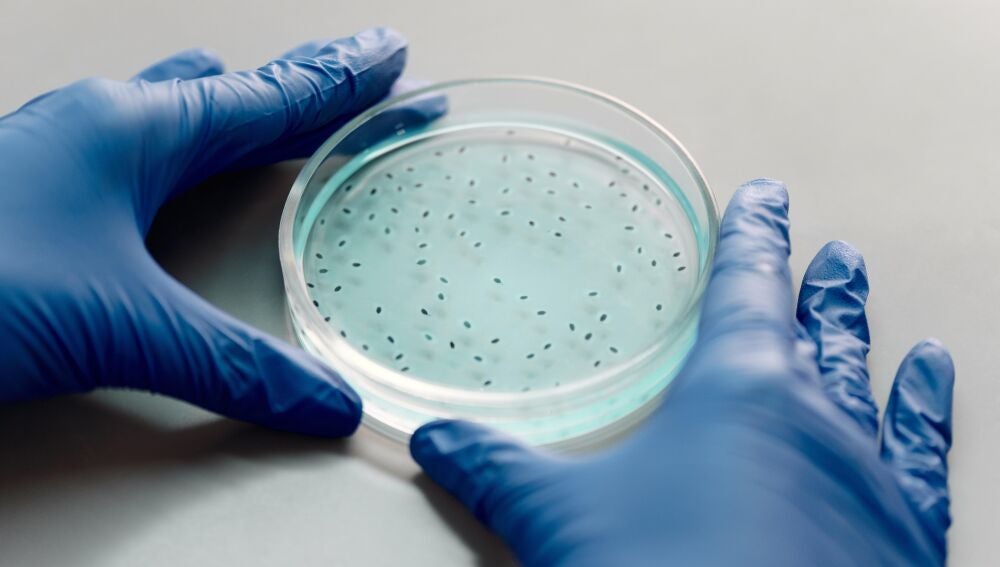

Investigadores del Centro Oncológico Fred Hutchinson de Seattle (Estados Unidos) revelan en dos estudios cómo las bacterias se infiltran en los tumores y podrían estar ayudando a que éstos progresen y se propaguen, a la vez que los diferentes actores microbianos en el microbioma de un tumor podrían influir en la forma en que un cáncer responde al tratamiento.
Los resultados también sugieren una relación entre la salud bucal y el cáncer, ya que los microbios de la boca están asociados a los cánceres de otras partes del cuerpo.
Ambos trabajos, uno publicado en la revista 'Cell Reports' y el otro en 'Nature', se centran en una bacteria bucal llamada 'Fusobacterium nucleatum', que se ha relacionado con el cáncer colorrectal.
Las células no cancerosas que rodean a un tumor pueden ayudarle a evitar los ataques del sistema inmunitario, a resistir las terapias dirigidas a ellas y a permitir que se extienda a otras partes del cuerpo.
Los investigadores están descubriendo que algunas de estas útiles vecinas ni siquiera son células humanas sino bacterias.
"Lo que estamos demostrando es que hay regiones del tumor que están fuertemente colonizadas por bacterias (regiones de micronichos) y que difieren funcionalmente de las regiones que no albergan bacterias. Y estas regiones ricas en bacterias tienen un mayor potencial metastásico", señala la investigadora del microbioma del cáncer de Fred Hutch y codirectora del estudio, Susan Bullman, refiriéndose al trabajo descrito en el estudio de 'Nature'.
Bullman y el microbiólogo molecular de Fred Hutch Christopher D. Johnston, combinaron las observaciones de los tumores con experimentos de laboratorio y pantallas de fármacos de moléculas pequeñas. Su objetivo era demostrar que la bacteria bucal 'F. nucleatum' puede posibilitar las condiciones en los tumores para mantenerlos a salvo del ataque inmunológico y ayudarlos a propagarse por el cuerpo.
Descubrieron que algunas terapias contra el cáncer funcionan porque no sólo se dirigen a las células tumorales, sino también a las bacterias que las ayudan.
Los investigadores también han descubierto que otros microbios (incluida la 'Escherichia coli') pueden volver ineficaz a un fármaco antimicrobiano y quimioterapéutico común llamado 5-fluorouracilo, lo que protegería tanto al tumor como a la bacteria 'F. nucleatum' del tratamiento.
Estos hallazgos podrían ayudar a los investigadores a desarrollar nuevas estrategias para tratar o atacar el cáncer abordando su microbioma.
Cómo se desarrollaron los estudios y qué han descubierto
La relación con las bacterias puede parecer lógica en el cáncer colorrectal, pero los tumores de mama, páncreas y pulmón son algunos de los cánceres que albergan comunidades microbianas, y los estudios demuestran que los microbiomas tumorales pueden influir en el desarrollo, la progresión y la respuesta al tratamiento.
El equipo adaptó una tecnología de vanguardia que permite detectar dónde se activan y desactivan los genes en cortes de tejido tumoral (transcriptómica espacial).
Los investigadores descubrieron que en los cánceres orales y colorrectales vivían una serie de especies bacterianas que no estaban repartidas uniformemente.
Se dieron cuenta que las regiones colonizadas por bacterias eran altamente inmunosupresoras y tenían menos células T cancerígenas que otras zonas.
Además, las zonas que tenían células T cerca de las bacterias también presentaban un aumento de la regulación de las proteínas del punto de control inmunitario, que restringen los efectos de las células T para matar el cáncer.
Se ha aprobado el uso de inhibidores de puntos de control en el cáncer colorrectal, y este estudio puede ayudar a explicar cómo la microbiota de un paciente puede influir en la respuesta de su cáncer a un inhibidor de puntos de control.
Los estudios descubrieron que las regiones con bacterias tenían más probabilidades de estar necrosadas y con menos células en división. Lo que, según otras investigaciones, puede relacionarse con la metástasis, ya que las células se desprenden y viajan a sitios distantes del cuerpo.
Observaron que las células tumorales infectadas con la bacteria aumentaron los genes asociados a la progresión del cáncer y la metástasis.
En las muestras de tumores orales, los investigadores vieron que las bacterias infectaban preferentemente las células epiteliales del cáncer y células inmunitarias específicas dentro de los tumores de los pacientes.
Esas células tumorales infectadas mostraban un aumento en señalización de daños en el ADN, un rasgo distintivo del cáncer.
Estos resultados apoyan que las bacterias tienen un papel directo en la formación de estas microrregiones, señalan los investigadores.
Por otro lado, algunos medicamentos contra el cáncer pueden ser eficaces porque también son antimicrobianos que atacan a las bacterias que favorecen el desarrollo de los tumores.
La bacteria 'F. nucleatum', promotora del cáncer, es muy sensible a un quimiofármaco común llamado 5-fluorouracilo (5-FU), pero los investigadores descubrieron que la bacteria 'E. coli' protegía a las células del cáncer colorrectal del 5-FU.
Al parecer, la bacteria 'E. coli' tiene una forma de metabolizar el fármaco 5-FU y minimizar su exposición a las células cancerosas o a otras bacterias.
El equipo de investigación seguirá explorando la posibilidad de hacer que los tumores respondan mejor a la inmunoterapia o la quimioterapia mediante la manipulación del microbioma, y busca diseñar terapias que modifiquen el microbioma para prevenir y tratar el cáncer y detener su propagación.